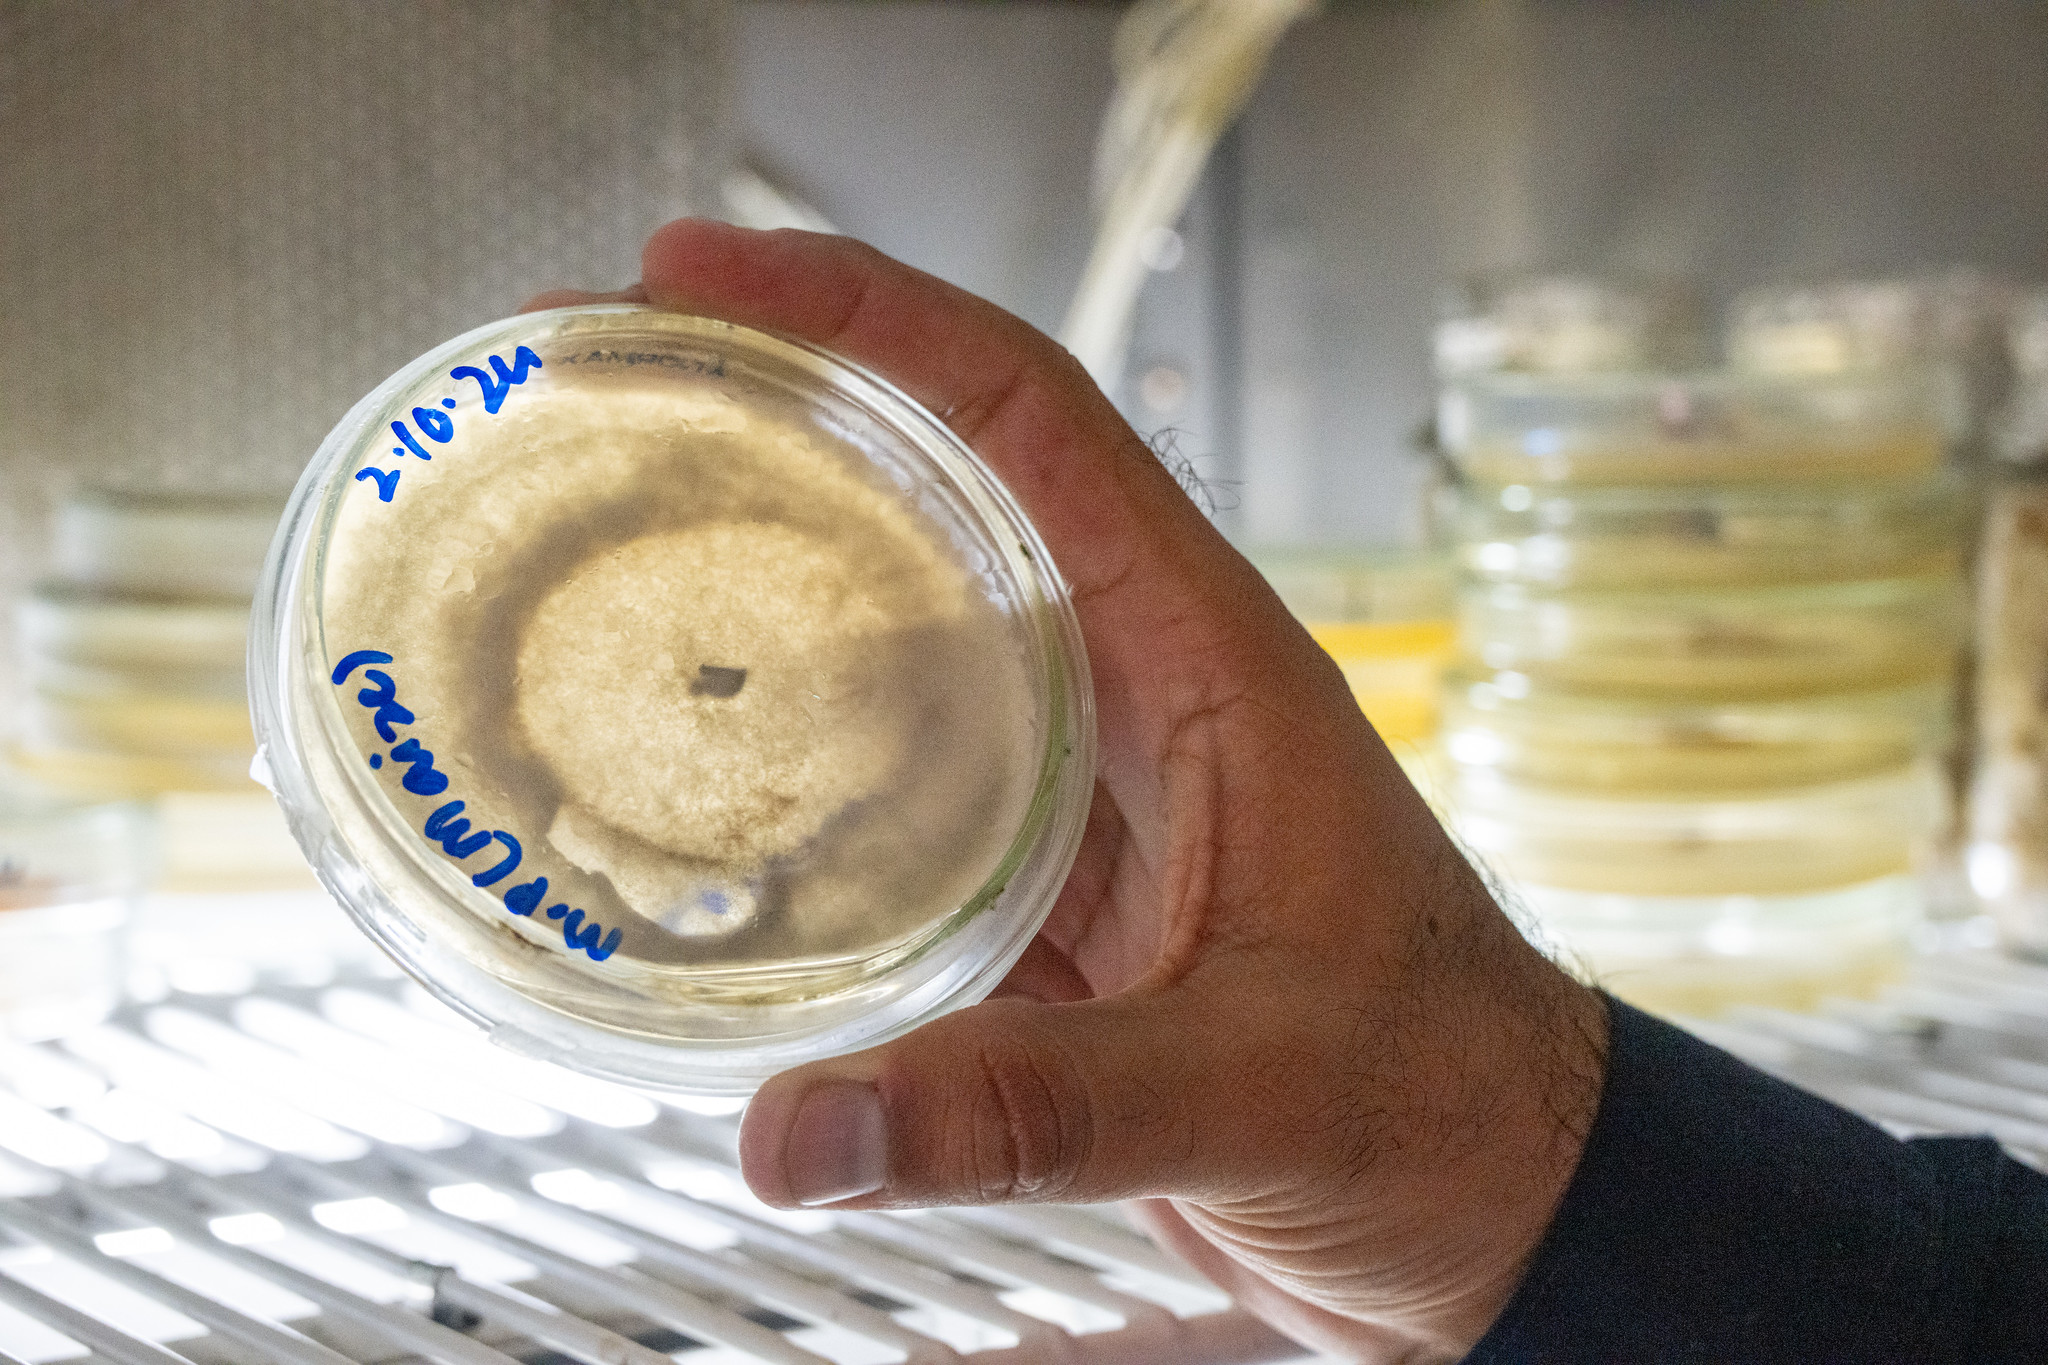
Seed Conditioning 106 - Caryover Seed, Inventory and Storage

Overview
Seed that comes from the field is never pure, it contains sticks, stems, debris, soil, weed and other crop seeds, trash, and insects. In its simplest form, conditioning is the process of cleaning the seed and removing impurities and contaminates so that the end user receives pure, high-quality seed ready for planting. This course is first in a series which will walk you through foundational concepts of seed conditioning.
Host
Colorado State University is one of the highest rated higher education institutions in Colorado. Through CSU online and CSU UpSkill, the University provides access to online and distance education to students and working professionals.
Read more